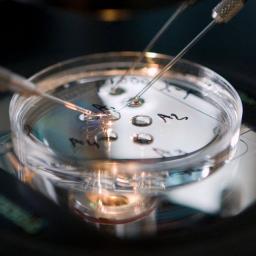

|
on (#4A4Z1)
Het gaat om een oliedeal van 1,3 miljard dollar uit 2011, aldus Shell. Een deel van het dat geld zou bij hoge ambtenaren beland zijn.
|
 Nieuws, achtergronden en onderzoeksjournalistiek - NRC
Nieuws, achtergronden en onderzoeksjournalistiek - NRC
| Link | https://www.nrc.nl/ |
| Feed | http://www.nrc.nl/rss.php |
| Copyright | Mediahuis NRC BV, Amsterdam. Deze RSS-feed is uitsluitend bedoeld voor persoonlijk, niet-commercieel gebruik. Op ieder gebruik van RSS-feeds van NRC zijn de Leveringsvoorwaarden van toepassing: https: |
| Updated | 2025-11-23 14:15 |
 |
on (#4A4Z3)
Volgens de minister van Volksgezondheid (CDA) moet de zorg in Nederland worden geherstructureerd. Hij wil een regionale organisatie waarin zorgverleners en -verzekeraars samenwerken met gemeenten, en er minder concurrentie is.
|
 |
on (#4A4Z5)
Doordat er meer dure e-bikes worden verkocht is de omzet van de fietsbranche sterk gestegen, melden Bovag en de RAI Vereniging.
|
 |
on (#4A4Z7)
Op het platteland van Lex Lokaal draait het leven om feesten met bier en dingen met motoren. Hij doet verslag van mensen die voldoen aan het boerencliché.
|
 |
on (#4A4TN)
Volgens de Amerikanen is hij een nieuwe leider binnen Al-Qaeda, het terreurnetwerk van zijn vader Osama bin Laden. Hij heeft de VS al eerder bedreigd met wraakacties voor de dood van Osama in 2011.
|
 |
on (#4A4TQ)
Na aanhoudende protesten heeft de Soedanese president een deel van zijn politieke macht opgegeven. Afgelopen week riep hij de noodtoestand uit en benoemde hij militairen op hoge posten.
|
 |
on (#4A4DE)
De Tilburgers bereikten voor het eerst in veertien jaar de bekerfinale, door AZ in de strafschoppenreeks te kloppen. De Alkmaarders misten vier van hun vijf penalty’s.
|
 |
on (#4A42Z)
Vrouwen rukken op in het voetbal. Maar op tv en in clubnamen als Drachtster Boys en Kozakken Boys zie je dat nog niet echt terug, zo valt Japke-d. Bouma op.
|
 |
 |
 |
on (#4A4P1)
De universiteit van Wageningen wil een contactverbod voor een man die medewerkers bedreigt. „I will kill you.â€
|
 |
on (#4A4P0)
Abrahams als hoofdredacteur van het NRC: maar dan wel met zijn vrouw.
|
 |
on (#4A4NY)
St Jansdal neemt vrijdag het failliete MC Zuiderzee in Lelystad over. Rond Lelystad zal straks acute zorg voor patiënten ontbreken.
|
 |
on (#4A4NW)
Pakistan laat een gevangen Indiase gevechtspiloot vrij en wil zo een ‘vredesbaar’ maken. India is daar niet erg van onder de indruk.
|
 |
 |
on (#4A42W)
De Israëlische premier wordt aangeklaagd voor corruptie. Maar eerst mag hij zich nog verdedigen tijdens een hoorzitting.
|
 |
on (#4A46P)
De totale productie van elektriciteit uit duurzame bronnen bleef wel stijgen, aldus het CBS.
|
 |
on (#4A46R)
De testdagen in Barcelona trekken een mix van die-hards en zij die er de perfecte introductie tot de sport in zien.
|
 |
on (#4A430)
Vorige week waren er al berichten over de vermoedelijke dood van Fabien Clain (41) bij een bombardement.
|
 |
on (#4A432)
Rijksuniversiteit Groningen mocht geen publiek geld stoppen in een campus in China. Nu blijkt: er is publiek geld gebruikt.
|
 |
on (#4A3Y9)
Rusland en China gebruikten hun doorslaggevende stemrecht om de Amerikaanse roep om “ongehinderde hulp†en “rechtvaardige verkiezingen†in Venezuela te voorkomen.
|
 |
on (#4A3YB)
De Franse regering is zo ontstemd over de Nederlandse steun voor KLM dat de herbenoeming van Elbers op het spel staat.
|
 |
on (#4A3YD)
Het is zijn tweede goud dit toernooi: woensdag zat hij al bij het team dat wereldkampioen werd op de teamsprint.
|
 |
on (#4A3YF)
Donderdag lekte uit dat de Ralf Krewinkel, burgemeester van Heerlen, solliciteerde op het burgemeesterschap van buurgemeente Kerkrade.
|
 |
on (#4A3YH)
Het vredesproces op het Koreaanse schiereiland is in nevelen gehuld, nu de ontmoeting tussen Noord-Korea en de VS onverwacht niets opleverde.
|
 |
on (#4A3TD)
Previns werk omvatte zowel klassieke muziek als jazz. Hij componeerde, speelde piano, dirigeerde onder meer het Concertgebouworkest en won vier Oscars.
|
 |
on (#4A3TF)
Lidl maakt met het hippe biermerk Kordaat géén inbreuk op dat andere hippe biermerk Kornuit, zo oordeelde de rechter donderdag. Net als eerder ook niet bij Vlugge Japie-koekrepen (Snelle Jelle) en chocoladekoekjes van Neo (Oreo).
|
 |
on (#4A3TH)
Nederland worstelt met de erbarmelijke situatie in de gevangenis op Sint Maarten. Na orkaan Irma zitten nog 23 gevangenen in Nederland.
|
 |
on (#4A3GH)
In twee staten in het noordwesten van het land vielen gewapende criminelen verschillende dorpen aan. President Buhari heeft het geweld veroordeeld.
|
 |
on (#4A3GK)
Het College voor de Rechten van de Mens wil intensief Europees toezicht op Nederland bij het verbeteren van de omstandigheden van gevangenen op Sint Maarten.
|
 |
on (#4A3BW)
Nu.nl weert al maanden reacties met ‘onwaarheden’ en specificeert dat nu met een verbod op ontkennen van klimaatverandering. Er kwam kritiek, maar ook bijval.
|
 |
on (#4A3BY)
Dat heeft de hoofdaanklager bekendgemaakt. Voor het zover is, mag Netanyahu zich nog verdedigen tijdens een hoorzitting.
|
 |
on (#4A3C0)
Ten minste 4 miljoen bezoeken was de bedoeling, het werden er ruim 5 miljoen. Leeuwarden-Fryslân Culturele Hoofdstad was een succes. Friesland wil cultuurprovincie blijven.
|
 |
on (#4A37H)
Buurtbewoners wonnen donderdag een kort geding, waardoor het voorbereidend werk nu ten minste vier maanden stil is komen te liggen.
|
|
on (#4A37K)
Zorgverzekeraars hoeven een vruchtbaarheidsbehandeling niet te vergoeden voor alleenstaande of lesbische vrouwen, schrijft minister Bruins. De betaalbaarheid van het basispakket zou erdoor onder druk komen te staan.
|
 |
on (#4A37N)
Voetbalclubs zijn sinds dit seizoen terughoudend als ze spreken over blessures. Wat iemand mankeert? Vraag het de speler zelf.
|
 |
on (#4A31T)
Voordat het stel op vakantie ging, sloot de man een verzekering af zodat hij 300.000 euro zou ontvangen als zijn vriendin zou overlijden.
|
 |
on (#4A31W)
De kinderen zijn geboren uit dezelfde eicel, maar twee verschillende zaadcellen. Het is pas de tweede keer dat een soortgelijke tweeling is gerapporteerd.
|
 |
on (#4A31Y)
Een verdachte werd in 2015 geboeid en gedwongen zijn duim tegen zijn iPhone te houden. Dat was volgens de rechter geoorloofd, omdat hij het onderzoek anders frustreerde.
|
 |
on (#4A31Z)
De jarenlange kaalslag op cultuur vanuit de overheid deed culturele instellingen zoeken naar andere geldstromen. De overheid wil daar nu bij helpen.
|
 |
on (#4A321)
Carolina Trujillo was bij ADO - Ajax en dacht: zolang de bal rolt, voelen fans het gewicht van de zak met stenen op hun rug niet.
|
 |
on (#4A322)
In Vincent Rietveld gaat voor de Louis d’Or van toneelcollectief De Warme Winkel ruziën de jonge en oude garde op geestige wijze over de waarde en de inhoud van theater.
|
 |
on (#4A324)
De grootmeester van de faction-thriller schreef een boek over een jonge hacker die wereldmachten tegen elkaar opzet.
|
 |
on (#4A325)
Bo Tarenskeen confronteert nazi-architect Albert Speer met een bewonderaar van de Bijlmerflats. In Speer wordt dat een atypisch gesprek over architectuur en uitgummen wat je niet bevalt.
|
 |
on (#4A2VV)
Oorspronkelijk wilde Marinus Boezem dat zijn ‘Groene Kathedraal’ bij Almere zou vervallen tot ruïne. Nu wordt het kunstwerk toch gerestaureerd.
|
 |
on (#4A2VX)
Vanwege het Rembrandtjaar heeft het Rijksmuseum de stem van de schilder gereconstrueerd. Hij klinkt een beetje als de Jeugd van Tegenwoordig in ‘Watskeburt’.
|
 |
on (#4A2VZ)
De schrijfster kreeg de P. C. Hooftprijs 2019 voor haar oeuvre, dat stoelt op haar oorlogservaringen. ‘Ik was kwaad, iedereen wilde vergeten.’
|
 |
on (#4A2R9)
De branden begonnen in 2014 met een verkeersbord en een stapel kranten en liepen uit tot autobranden en brandstichtingen in schuren en woningen.
|
 |
on (#4A2RB)
Een overzicht van de series en films die op Netflix, Videoland en elders verschenen.
|
 |
on (#4A2RD)
Forum voor Democratie wil zich na de Europese verkiezingen bij de ECR-fractie voegen. De ChristenUnie verzet zich tegen de komst van Baudet, die een ‘Nexit’ bepleit.
|